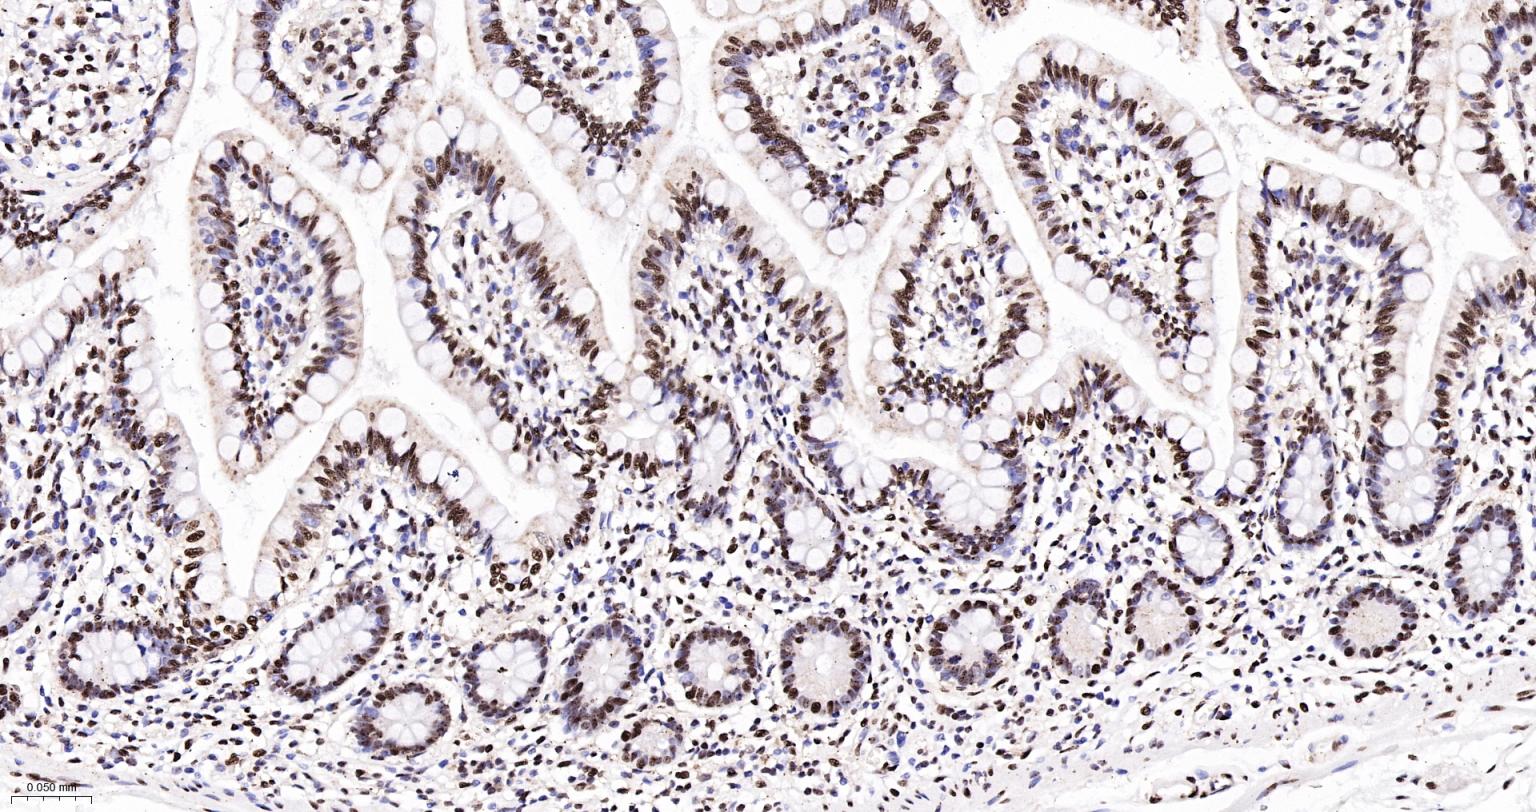
扑克蒙蛋白重组兔单抗

扑克蒙蛋白重组兔单抗
Rrmab?兔单抗

货号:bsm-62165R
产品详情
相关标记
相关产品
相关文献
常见问题
概述
产品编号
bsm-62165R
产品类型
重组兔单抗、mIHC精品抗体
英文名称
Pokemon/ZBTB7A Recombinant Rabbit mAb
中文名称
扑克蒙蛋白重组兔单抗
英文别名
FBI-1; FBI1; LRF; MNDLFH; TIP21; ZBTB7; ZNF857A; pokemon; 9030619K07Rik; 9130006G12Rik; ZBT7A_HUMAN; ZBTB7A; Factor binding IST protein 1 (FBI-1); Factor that binds to inducer of short transcripts protein 1; HIV-1 1st-binding protein 1; Leukemia/lymphoma-related factor; POZ and Krueppel erythroid myeloid ontogenic factor (POK erythroid myeloid ontogenic factor | Pokemon | Pokemon 1); TTF-I-interacting peptide 21 (TIP21); Zinc finger protein 857A; ZBT7A_MOUSE; POZ and Krueppel erythroid myeloid ontogenic factor (POK erythroid myeloid ontogenic factor | Pokemon);
抗体来源
Rabbit
免疫原
A synthesized peptide derived from human ZBTB7A: 520-584
亚型
IgG
性状
Liquid
纯化方法
affinity purified by Protein A
克隆类型
Recombinant
克隆号
2B1
理论分子量
61 kDa
检测分子量
70 kDa
储存液
10mM phosphate buffered saline(pH 7.4) with 150mM sodium chloride, 0.05% BSA, 0.02% Proclin300 and 50% glycerol.
SWISS
Gene ID
保存条件
Store at 4℃ for short term. Store at -20℃ for long term. Avoid repeated freeze/thaw cycles.
注意事项
This product as supplied is intended for research use only, not for use in human, therapeutic or diagnostic applications.
数据库链接
产品介绍
Pokemon(7APOK Erythroid Myeloid Ontogenic factor)能够控制将正常细胞变成癌细胞所需的途径,Pokemon蛋白是转录因子蛋白家族的一员,并且在人类癌症中发生了突变。另外Pokemon蛋白作为转录因子参与一些细胞基因转录的调节,并在细胞分化过程中发挥着关键、多效性的功能。近来发现,Poke-mon在致癌转化过程中发挥着至关重要的功能,并与肿瘤的发生密切相关。
这种蛋白很可能在实质肿瘤中处于重要地位,还有学者认为:Pokemon在一定类型的B细胞和T细胞淋巴瘤中水平非常高,并发现具有高水平Pokemon蛋白表达对肿瘤恶性程度改变更大。
主要定位于细胞核。
扑克蒙”蛋白又称“波克曼”蛋白。
这种蛋白很可能在实质肿瘤中处于重要地位,还有学者认为:Pokemon在一定类型的B细胞和T细胞淋巴瘤中水平非常高,并发现具有高水平Pokemon蛋白表达对肿瘤恶性程度改变更大。
主要定位于细胞核。
扑克蒙”蛋白又称“波克曼”蛋白。
背景资料
Transcription factor that represses the transcription of a wide range of genes involved in cell proliferation and differentiation.

产品应用
| 应用 | 已检合格种属 | 预测种属 | 推荐稀释比例 |
|---|---|---|---|
| WB | Human | 1:1000-2000 | |
| IHC-P | Human | 1:200-800 | |
| IHC-F | Human | 1:200-800 | |
| IF | Human | 1:200-800 | |
| Flow-Cyt | Human | 1:50-100 | |
| ICC/IF | Human | 1:100-500 | |
| IP | Human | 1:20-50 |
交叉反应
交叉反应: Human
相关产品
暂无相关产品
靶标
基因名
ZBTB7A
蛋白名
Zinc finger and BTB domain-containing protein 7A
亚基
Interacts with BCL6.
亚细胞定位
Nucleus.
组织特异性
Widely expressed. In normal thymus, expressed in medullary epithelial cells and Hassle's corpuscles (at protein level). In tonsil, expressed in squamous epithelium and germinal center lymphocytes (at protein level). Up-regulated in a subset of lymphomas, as well as in a subset of breast, lung, colon, prostate and bladder carcinomas (at protein level).
相似性
Contains 1 BTB (POZ) domain.
Contains 4 C2H2-type zinc fingers.
Contains 4 C2H2-type zinc fingers.
功能
Plays a key role in the instruction of early lymphoid progenitors to develop into B lineage by repressing T-cell instructive Notch signals (By similarity). Specifically represses the transcription of the CDKN2A gene. Efficiently abrogates E2F1-dependent CDKN2A transactivation/de-repression. Binds to the consensus sequence 5'-[GA][CA]GACCCCCCCCC-3'.
标记抗体
暂无标记数据
同靶标产品
暂无同靶标产品
相关文献
提示: 发表研究结果有使用 bsm-62165R 时请让我们知道,以便我们可以引用参考文章。作为回馈,资料提供者将获得我们送上的小礼品。
暂无相关文献
常见问题
暂无常见问题